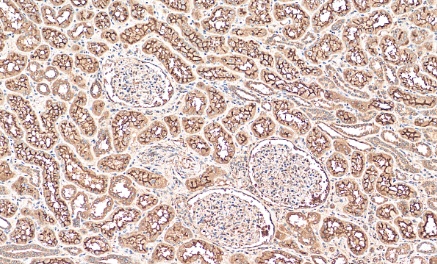
1

| 经过测试的应用 | |
| WB | |
| IHC | |
| 反应物种 | human, mouse |
| 抗体类型 | Primary antibody |
| 免疫原 | Product name: Recombinant human SLC13A2 protein Source: e coli.-derived, PGEX-4T |
| 偶联类型 | Unconjugated |
| 克隆性 | Polyclonal |
| 宿主 | Rabbit / IgG |
| 基因名 | SLC13A2 |
| 纯化方式 | Antigen affinity purification |
| 分子量 | 64 kDa |
| 形式 | Liquid |
| 存储缓冲液 | PBS with 0.02% sodium azide and 50% glycerol, pH 7.3 |
| 储存 | Store at 4°C short term. Aliquot and store at -20°C long term. Avoid freeze/thaw cycles. |
Immunohistochemical analysis of paraffin-embedded human kidney tissue slide using (SLC13A2 antibody) at dilution of 1:200 (under 10x lens)

Immunohistochemical analysis of paraffin-embedded human kidney tissue slide using (SLC13A2 antibody) at dilution of 1:200 (under 40x lens)

Immunohistochemical analysis of paraffin-embedded mouse kidney tissue slide using (SLC13A2 antibody) at dilution of 1:1000 (under 40x lens)
×